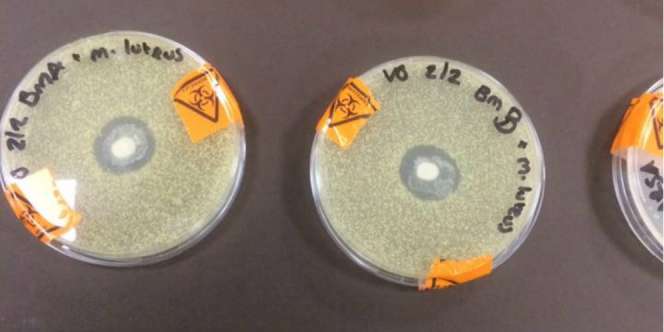

ASI (putih Di Tengah) Mampu Menahan Perkembangan Bakteri.
Dream - Sudah banyak penelitian yang membuktikan kalau air susu ibu (ASI) memiliki efek dahsyat bagi bayi. Bukan hanya memberikan asupan nutrisi tapi juga membuat perlindungan maksimal pada tubuh bayi.
ASI ternyata memiliki efek signifikan dalam membentuk antibodi dan membantu bayi dalam melawan infeksi. Hal ini terlihat dalam penelitian yang Vicky Greene seorang mahasiswa jurusan
biomedis.
Vicky sedang melakukan penelitian mikrobiologi. Ia tertarik untuk mengetahui respons ASI pada bakteri. Dengan menggunakan bakteri M Luteus, Vicky menaruhnya dalam kaca petri bulat, bersamaan dengan ASI.
" Sample pertama adalah ASI dari ibu yang memiliki bayi 15 bulan (BmA) dan sample kedua adalah ASI yang berasal dari ibu yang memiliki anak usia 3 tahun (BmB). Aku juga meneliti kolustrum (ASI yang keluar di 2 hari pertama setelah melahirkan)," tulis Greene di akun Facebooknya.
Dalam penelitiannya terdapat 9 petri hidangan yang mengandung bakteri M. luteus. Bintik-bintik putih di tengah adalah cakram yang direndam dalam dua sampel ASI. Terlihat jelas di area sekitar cakram, di mana mana protein dalam ASI menghambat pertumbuhan bakteri.
" Aku sangat gembira!!! Hal ini juga bekerja sama pada E. coli dan bekerja sangat baik pada bakteri MRSA. Masa depan cerah, masa depan adalah ASI," tulis Greene.
Laporan: Gemma Fitri Purbaya